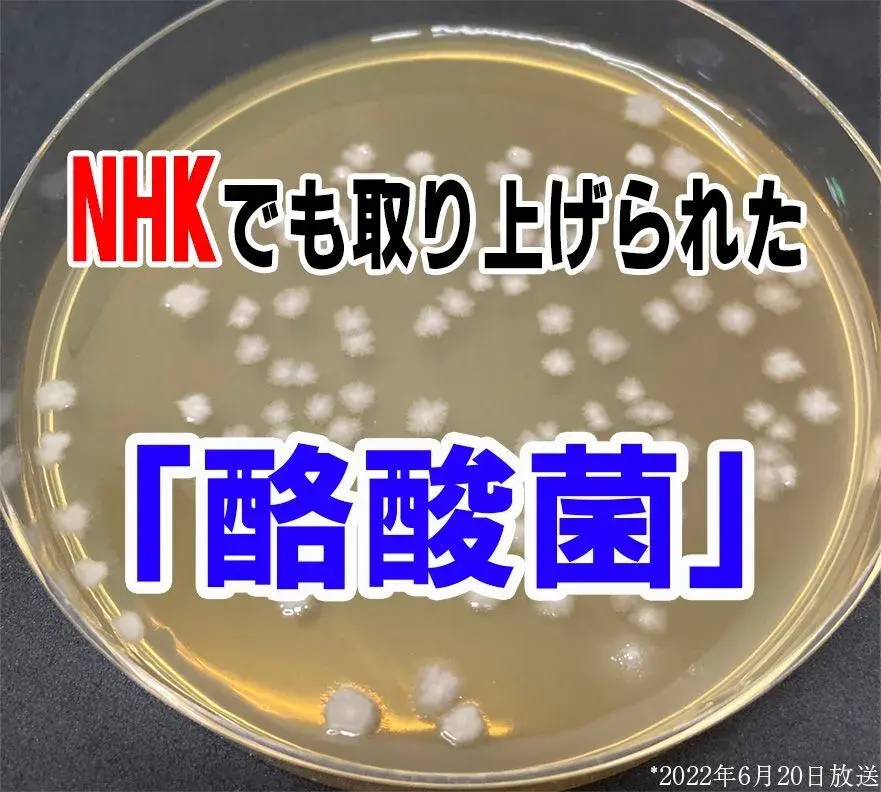

※適度な食事制限と運動を併用
みなさんご存知ですか?
体重・体脂肪を落とす「新美腸活」で
美ボディになる中高年女性が続出
しているんです!
実はこれ、
杉原彩さんの
「美ボディの秘訣」で、
NHK特集された「奇跡の菌」を
使ったものなんです!※
※2022年6月20日放送

その実力は、大ヒット腸活本の
著者の名医も絶賛するほど!

だから、太りやすい中高年から
「ラクに体重が落ちた!」※
「腸活で美ボディを作れるなんて!」
と喜ぶ女性が続出!
実力を示すかのように、
いち早く聞きつけた多くの女性が殺到して、
数々のタイトルを総なめ!

さらに、多数の雑誌に掲載されていて、
※美ST 2023年6月掲載※&ROSY_23年8月号掲載※steady_2023年4月掲載
他の一流の女優たちもこぞって愛用するほど!

長年スリムになれなかった女性の間で、
今絶賛、話題沸騰中の美腸活なのです!
ウエスト周りもスッキリ!
(54歳 小林さん)
(54歳 小林さん)

毎日の習慣として、腸活を始めました。
このサプリを1日1粒目安で飲み始めてからスッキリしました!
※個人の感想であり、効果には個人差があります。
※食事管理と運動の併用による。
※食事管理と運動の併用による。
カラダの中から綺麗に
(46歳 彩華さん)
(46歳 彩華さん)
私のインナーケアにもってこいだとピンときました。
美腸を手に入れて、カラダの中から綺麗になりました!
※個人の感想であり、効果には個人差があります
体のラインが見える服も!
(50歳 酒井さん)
(50歳 酒井さん)

すっかり朝の日課になって、手軽に続けられました。
気になっていたウエストもいい感じで、
体のラインが見える服も自信を持って着れています!
※個人の感想であり、効果には個人差があります
なんと、医師も”この方法を大絶賛!”
「この菌を取れるなんて希少
!
」
「いつも
お世話になってます」
この日本唯一の方法を開発したのは、
東大卒社長が率いる
菌活企業!
杉本さんが愛用するのも納得ですね!
とはいえ、
ツライ食事制限・筋トレをしても
体重を減らすのも難しいのに・・・

ジムにもいかず簡単に美ボディになれるの?
でも、、、
「本当に変わるのならやりたい!」
藁にもすがる思いで試してみると
1日1粒目安だけで...
嘘でしょーーー!?✨
元々70キロあった体重が!

70代ママも
見違えるほどスッキリ!❤️
なぜ、ここまで違いが生まれるのか!?
”彩さんの美ボディの秘訣”
新美腸活のヒミツとは・・!
POINT 体重・体脂肪を減らす新美腸活!
そのヒミツを大公開!
どれだけ頑張っても減らない理由。
誘惑を我慢する気持ちの強さ??
否!!
あなたは悪くないんです!
実は、体重と体脂肪に深く関係するのは、
善玉菌と悪玉菌のバランス!

つまり、美ボディーなるためには
善玉菌と悪玉菌のバランス
が
重要なんです!
そこで注目されているのが、
”奇跡の善玉菌”※
「酪酸菌」
この菌が生きて腸内に届いて、
スリム体型の腸内バランスに
導くんです!※
※便秘気味の方が対象
しかも!※
体重と体脂肪を減らしてくれる!
※肥満気味の方の酪酸菌とHMPAの同時摂取が体重減少をサポートすること
さらに、

という研究報告もされています!

※画像はイメージです
こんなに重要な菌なのですが・・・

そのため、
体重や体脂肪を減らしたい人は
外から摂取しないとダメ!
しかし、食事からだと
何キロも食べなくてはならず非現実的...
なんとか簡単に摂取できる方法がないか?
長年の研究の末、誕生したのが!
彩さんの美ボディーの秘訣!
\ラクビプレミアム/
酪酸菌を”1400万個”も凝縮している、
日本唯一*
機能性表示食品なんです!
*酪酸菌を機能性関与成分として配合した機能性表示食品(2022年8月消費者庁データベースより)

さらに、6000種類以上ある機能性表示食品の中でも
ほんの一握りの厳しい方法で、
機能性が報告されている商品なんです!

だから、
「体重・体脂肪・ウエスト」の減少が
しっかり証明されているんです!※
※肥満気味の方の酪酸菌とHMPAの同時摂取が体重減少をサポートすること

この結果は
論文にも掲載されるほど!

だから、キツい対策で挫折してきた方も!
”ラクラク”美ボディーが
手に入るんです!❤️
加えて、
完全国内製造と丁寧に作られていて、
カラダにいいもの大賞も
2年連続受賞しているから安心!

だから、彩さんも
オススメするほどの商品なのですね!

私の体型に驚いた娘も
「ママが変わったなら私も!」と実践!
1日1粒目安で
お腹周りが”キュッ”
「試してよかったぁ〜!❤️」
って感動してました
※対策の時間
彩さん秘訣のラクビプレミアムで
綺麗な人が続出するのも納得です!
お腹までびっくり!
気持ちもスッキリです!ラクビを飲み始めて、本当にびっくりです。今までずっと気になっていた便秘気味のぽっこりお腹まで!整腸は健康に繋がるので続けていきたいです!
※個人の感想で効果効能を保証するものではありません※自社モニター
美味しい食事が大好きなので嬉しい!この歳でも、諦めないでよかったです。
今までは、食べたいのに我慢して食事制限をしていました。ラクビは1日一粒目安で、お値段もお手頃なので続けられそうです。
※個人の感想で効果効能を保証するものではありません※自社モニター
これと出会ってから怖いもの知らずです!これと出会ってから怖いもの知らずです!本当に。笑
※個人の感想で効果効能を保証するものではありません※自社モニター
スッキリして気にならなくなってきました。
60代になっても頼れる味方です。
1日一粒目安で調子も整うので嬉しい限りです。
これだけ多くの綺麗な女性が続出する
美腸活で美ボディを手に入れましょう!
では最後に,
超お得にゲットできる裏技を
お伝えします!
そんな、
こだわり抜かれたラクビプレミアムは
定価で3,480円。
それでも安い!
なんて声も多いのですが…
たった30秒のアンケートに答えると!

*定期初回
なんと、さらに本日80%オフ!
直接販売しているからこそ、
実現できました!
他のサイトと比較しても、
どこも定価でしか購入できません。

私は定価で買ってしまったので、
ここから買えば良かったと後悔しました.....

ここからなら、
本日80%オフで680円で購入できます!
しかもなんと、
送料も無料!

1日たったの約22円。

で手に入るんです...!
安い代わりに
「◯ヶ月は解約できない」
とかもありません!

さらに
コンビニ払いも選べるので、
クレカは不要!

商品が届いてから後払いできるので安心ですね!
初回たった680円*で買える
この機会を逃すのは
本当にもったいないです....!
*定期初回
いつ在庫がなくなるか分かりません。
在庫がなくなり次第、
入荷をお待ちいただくことがございます。
入荷をお待ちいただくことがございます。
美ボディを手に入れたい*あなたは
アンケートに答えて、
大特価で実感してみてください!
*BMIが高めの人が対象
今すぐアンケートに答えて
お得にゲット!
Q1.ラクビプレミアムを知っていましたか?

Loading...
Q2.脂肪を減らしたいと実感する瞬間は?

Loading...
Q3.脂肪が減ったら期待することはなんですか?

Loading...
Q4.ラクビプレミアムの特徴で最も魅力的なものはなんですか?

Loading...
*便秘気味の方が対象 *肥満気味の人が対象
Q5.ラクビプレミアムを始めてみたいですか?

Loading...


本日80%オフはこちらから!

POINT 飲みやすいし、
何より手軽!
1日一粒目安で手軽!
外食だってラクビプレミアムがあれば楽しめる!
これなら
自然と毎日続けられます!
変化を実感している人が多いのも納得...
「ラクに体重を減らしたいならこれ一択よ!」

旅行やショッピングだって
心の底からより楽しめる
綺麗な自分を手に入れましょう!





